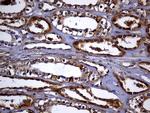
TXNRD1 Antibody in Immunohistochemistry (Paraffin) (IHC (P))

Search
OriGene
TXNRD1 Monoclonal Antibody (OTI7B2), TrueMAB™
{{$productOrderCtrl.translations['antibody.pdp.commerceCard.promotion.promotions']}}
{{$productOrderCtrl.translations['antibody.pdp.commerceCard.promotion.viewpromo']}}
{{$productOrderCtrl.translations['antibody.pdp.commerceCard.promotion.promocode']}}: {{promo.promoCode}} {{promo.promoTitle}} {{promo.promoDescription}}. {{$productOrderCtrl.translations['antibody.pdp.commerceCard.promotion.learnmore']}}
产品信息
TA811366
种属反应
宿主/亚型
分类
类型
克隆号
抗原
偶联物
形式
浓度
规格
纯化类型
保存液
内含物
保存条件
运输条件
靶标信息
This gene encodes a member of the family of pyridine nucleotide oxidoreductases. This protein reduces thioredoxins as well as other substrates, and plays a role in selenium metabolism and protection against oxidative stress. The functional enzyme is thought to be a homodimer which uses FAD as a cofactor. Each subunit contains a selenocysteine (Sec) residue which is required for catalytic activity. The selenocysteine is encoded by the UGA codon that normally signals translation termination. The 3' UTR of selenocysteine-containing genes have a common stem-loop structure, the sec insertion sequence (SECIS), that is necessary for the recognition of UGA as a Sec codon rather than as a stop signal. Alternative splicing results in several transcript variants encoding the same or different isoforms.
仅用于科研。不用于诊断过程。未经明确授权不得转售。
篇参考文献 (0)
生物信息学
蛋白别名: gene associated with retinoic and IFN-induced mortality 12 protein; Gene associated with retinoic and interferon-induced mortality 12 protein; GRIM-12; KM-102-derived reductase-like factor; MGC9145; NADPH-dependent thioredoxin reductase; oxidoreductase; Peroxidase TXNRD1; redox enzyme; selenoprotein oxidoreductase; selenoprotein TXNRD1; testis tissue sperm-binding protein Li 46a; Thioredoxin reductase 1, cytoplasmic; thioredoxin reductase GRIM-12; Thioredoxin reductase TR1; TR; TR alpha; TXNRD1; unnamed protein product
基因别名: GRIM-12; GRIM12; KDRF; TR; TR1; TRXR1; TXNR; TXNR1; TXNRD1
UniProt ID: (Human) Q16881, (Mouse) Q9JMH6
Entrez Gene ID: (Human) 7296, (Rat) 58819, (Mouse) 50493